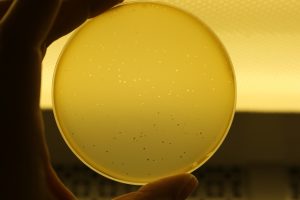
bacteriofagos

El grave problema de la resistencia bacteriana a antibióticos y biocidas necesita soluciones alternativas. Una de ellas son los virus que atacan y matan de forma especifíca determinados tipos de bacterias: los bacteriófagos (fagos). No sólo en la medicina sino también en la industria alimentaria, los fagos prometen como tecnología de biocontrol de patógenos en verduras y alimentos listos para el consumo.
Virus contra bacterias
Los bacteriófagos son virus abundantes en la naturaleza y forman parte de la microflora natural en humanos, plantas y animales.
Los bacteriófagos son virus abundantes en la naturaleza y forman parte de la microflora natural en humanos, plantas y animales.
Lo que los hace muy especiales es que atacan y matan específicamente a determinados tipos de bacterias. Por ejemplo, los fagos que infectan a E.coli O157:H7 solamente lo hacen exactamente a E.coli O157:H7 y no a otros tipos de E.coli o a otras bacterias presentes en su entorno.
Tras décadas de uso intensivo de toneladas de antibióticos, y de la aparición de resistencias frente a estos compuestos en las bacterias, los fagos se presentan como un arma de biocontrol con potencial para desarrollar alternativas a esta situación.
Y no sólo en el campo de la medicina, sino también en la industria alimentaria, especialmente para la reducción de patógenos en verduras y alimentos listos para el consumo.
¿Porqué en las verduras?
La tendencia entre los consumidores hacia una mayor conciencia de lo que comen, del origen de los alimentos, de cómo estos son procesados y de los aditivos que contienen, hace que las verduras con un procesado mínimo sean una opción ideal para muchos de estos consumidores.
Sin embargo, las verduras frescas que se consumen crudas son una fuente potencial de enfermedades transmitidas por los alimentos, ya que no son sometidas a ningún tratamiento que elimine de forma efectiva los patógenos.
Algunos factores que pueden influenciar la contaminación de las verduras frescas con patógenos son el agua de riego contaminada, el uso de estiercol como fertilizante, equipos de cosecha contaminados o malas prácticas de higiene de los trabajadores en el campo y en las plantas de envasado o procesado.
Aunque la industria alimentaria es muy consciente de estos riesgos y en los últimos años se han mejorado muchisimo los procedimientos de seguridad, todavía se producen brotes alimentarios asociados al consumo de verduras.
Entre los principales patógenos responsables de estos brotes se encuntran los serogrupos de E.coli productora de Toxinas Shiga (O26, O45, O111, O103, O121, O145 y O157: H7), asi como Salmonella y Listeria monocytogenes.
La contaminación de verduras con estas bacterias se produce con su unión al tejido vegetal. Por ejemplo, estudios han mostrado que E. coli O157: H7 prefiere unirse a los bordes de corte de la verdura en lugar de a las hojas enteras, que puede unirse al vegetal en un período corto de tiempo y que sólo puede eliminarse parcialmente con lavados de agua clorada. Sin embargo, tan sólo unas pocas células de E.coli productora de toxina shiga ya pueden causar enfermedad.
Por lo tanto, son necesarios métodos alternativos para disminuir o eliminar estos patógenos de los productos frescos.
Cóctel de bacteriófagos
Los bacteriófagos tienen la capacidad de controlar los patógenos transmitidos por los alimentos de una manera única, infectando las células bacterianas, destruyendo las bacterias y produciendo más fagos que pueden repetir el ciclo.
También han demostrado ser eficaces en la reducción de Salmonella, E. coli O157: H7 y Listeria monocytogenes en los alimentos.
Un estudio realizado en la Universidad de Manitoba (EEUU) y centrado en investigar fagos que reducen la presencia de E.coli productora de toxina shiga en verduras frescas, comprobó la efectividad de ocho fagos originarios de estiércol de ganado vacuno, ya que los siete serotipos patogénicos específicos de E. coli se encuentran a menudo en estiércol de ganado vacuno y los fagos florecen alli donde prosperan sus bacterias específicas.
Después de aislarlos y purificarlos, los multiplicaron a miles en el laboratorio. Finalmente agruparon los ocho tipos de fagos para producir un combinación más efectiva.
Para evaluar la eficacia de este cóctel, primero se verificó si sería capaz de matar a las bacterias a una temperatura de refrigeración utilizada para almacenar verduras frescas (2ºC). Tras aplicar una mezcla de los siete serotipos de E.coli sobre lechuga para simular la contaminación, observaron la acción de los fagos.
Los resultados mostraron que la mezcla de bacteriófagos especificos para E.coli pueden controlar algunos de los seis serogrupos en la lechuga contaminada. Se mostró muy eficaz contra E. coli O157: H7, O145, y O26, serogrupos que se asocian con frecuencia a brotes de infecciones alimentarias. Por lo que los autores consideran que esta actividad fágica tiene potencial para ser adoptada por la industria alimentaria para reducir los riesgos asociados a los productos frescos.
Especialmente interesante en el estudio fué descubrir que estos fagos en particular son más eficaces a temperaturas de refrigeración, ya que normalmente se considera que los bacteriófagos son más eficaces a 25-37ºC
Los autores apuntan que una desventaja de los fagos es que pueden tener potencialmente virulencia o genes de resistencia a antibióticos, por lo que hacen hincapié en la necesidad de asegurarse, mediante la secuenciación del genoma completo, de que los fagos utilizados en alimentos no portan genes indeseados.
El problema del desarrollo de resistencia puede superarse utilizando múltiples fagos en una mezcla, ya que esta acción sobrepasa la capacidad defensiva de la bacteria mediante los múltiples ataques de los diferentes fagos.
La aplicación del cóctel de fagos puede realizarse durante el lavado de la verdura y/o las etapas de envasado, sin alterar el sabor, el color o el aroma de los productos frescos.
Fuente: Foodqualityandsafety.com

